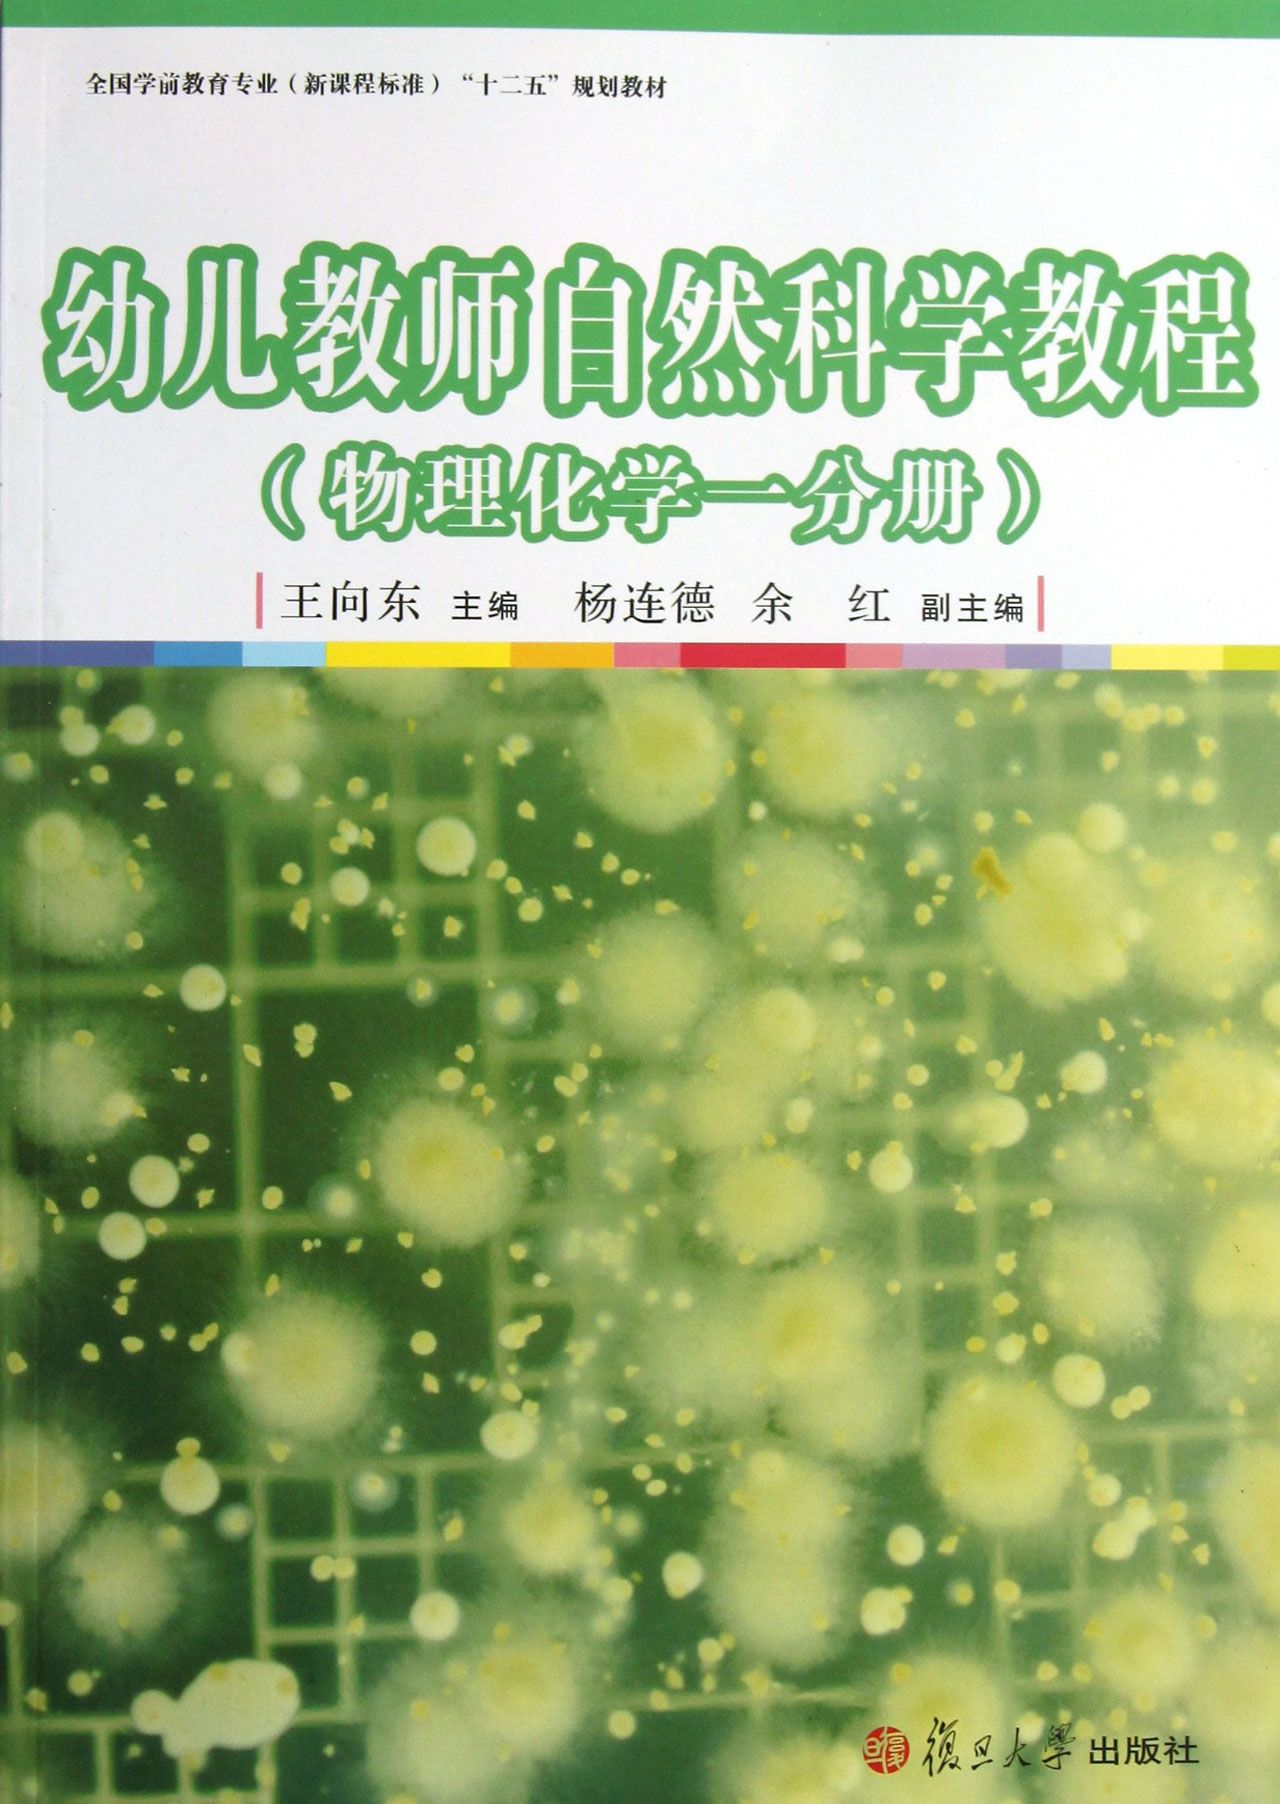

购物指南
| 普通信息 | |
|---|---|
| 商品编码(ISBN) | 9787309100853 |
| 出版时间 | 2013-10-01 |
| 出版社 | 复旦大学出版社 |
| 作者 | 王向东 |
| 发行范围 | 公开发行 |
| 页数 | 131 |
| 印数 | 4100 |
| 重 | 0.342 |
| CIP核字 | 2013226181 |
| 高 | 9 |
| 正文语种 | 汉 |
| 媒质 | 图书 |
| 用纸 | 普通纸 |
| 是否注音 | 否 |
| 是否套装 | 单册 |
| 开本 | 16开 |
| 影印版本 | 原版 |
| 印刷时间 | 2013-10-01 |
| 包装 | 平装 |
| 出次 | 1 |
| 字数 | 269 |
| 出版商国别 | CN |
| 中图法分类号 | N43 |
| 首版时间 | 2013-10-01 |
| 印张 | 8.75 |
| 印次 | 1 |
| 出地 | 上海 |
| 宽 | 209 |
| 长 | 295 |
| 读者对象 | 青年(14-20岁),普通成人 |




京公网安备 11010202007572号 丨 京ICP证 京B2-20171652号 丨 京ICP备16042375号-2
出版物经营许可证 新出发 京批字第直200352号 丨 互联网药品信息服务资格证书编号:(京)-非经营性-2022-0045
Copyright © 2015 - 2024 新华互联电子商务有限责任公司 版权所有
客服热线:4006666505
注册地址:北京市西城区北礼士路135号39号楼1层101、2层201